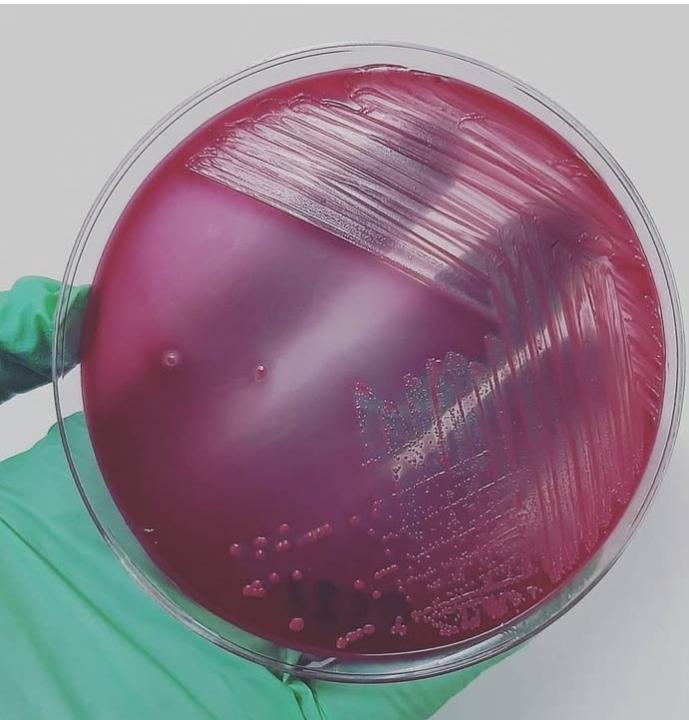
Claudia Cabrera

Activity
Mon
Wed
Fri
Sun
Jan
Feb
Mar
Apr
May
Jun
Jul
Aug
Sep
Oct
Nov
Dec
What is this?
Less
More
Memberships
Escaladores Financieros
478 members • Free
Contributions
@claudia-cabrera-6813
Soy emprendedora tengo un lab de ensayos me gustaria conocer mas de inversiones para crear ingresos pasivos
Active 4d ago
Joined Dec 6, 2025
Powered by